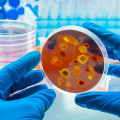

Լրահոս
 -17. առաջիկա օրերի եղանակային կանխատեսումը
-17. առաջիկա օրերի եղանակային կանխատեսումը
 Հարևանից ոսկյա զարդեր գողացած 43-ամյա տղամարդը ձերբակալվել է
Հարևանից ոսկյա զարդեր գողացած 43-ամյա տղամարդը ձերբակալվել է
 Անհատական շարժունակության միջոցներով երթևեկությանը ներկայացվող պահանջների խախտումը կառաջացնի տուգանքի նշանակում
Անհատական շարժունակության միջոցներով երթևեկությանը ներկայացվող պահանջների խախտումը կառաջացնի տուգանքի նշանակում
 Արարատի, Արթիկի, Անիի և Հրազդանի տարածաշրջաններում մառախուղ է, տեսանելիությունը՝ 50-100 մետր
Արարատի, Արթիկի, Անիի և Հրազդանի տարածաշրջաններում մառախուղ է, տեսանելիությունը՝ 50-100 մետր
 Բերման են ենթարկել «Հոկտեմբերյանցի Նովոյի» որդուն և ևս մի քանի հոգու
Բերման են ենթարկել «Հոկտեմբերյանցի Նովոյի» որդուն և ևս մի քանի հոգու
 Երևանում 37-ամյա վարորդը «Toyota Camry»-ով վրաերթի է ենթարկել կին հետիոտնի․ վերջինը տեղափոխվել է հիվանդանոց
Երևանում 37-ամյա վարորդը «Toyota Camry»-ով վրաերթի է ենթարկել կին հետիոտնի․ վերջինը տեղափոխվել է հիվանդանոց
 Համաճարակաբանը նշել է մետապնևմովիրուսի և սեզոնային գրիպի տարբերությունները
Համաճարակաբանը նշել է մետապնևմովիրուսի և սեզոնային գրիպի տարբերությունները
 Ապարանում ամուսինները գողացել էին տոնական խաղալիքներ․ նրանք խոստովանել են ու վերադարձրել 54 խաղալիքները
Ապարանում ամուսինները գողացել էին տոնական խաղալիքներ․ նրանք խոստովանել են ու վերադարձրել 54 խաղալիքները
 Յուրաքանչյուրն, ով Լոս Անջելեսում է, հնարավոր վտանգի տակ է. մոլեգնող հրդեհի՝ հայ արտիստների արձագանքները
Յուրաքանչյուրն, ով Լոս Անջելեսում է, հնարավոր վտանգի տակ է. մոլեգնող հրդեհի՝ հայ արտիստների արձագանքները
 Ինչ իրավիճակ է հանրապետության ճանապարհներին
Ինչ իրավիճակ է հանրապետության ճանապարհներին
 Ութ փաթեթ ափիոն․ Վաղարաշապատի համայնքնային ոստիկանների բացահայտումը
Ութ փաթեթ ափիոն․ Վաղարաշապատի համայնքնային ոստիկանների բացահայտումը
 Ուշագրավ դեպք Երևանում. ծննդաբերությունից հետո կինը «ծննդաբերել է» երեխայի գլխի չափով միամատոզ հանգույց
Ուշագրավ դեպք Երևանում. ծննդաբերությունից հետո կինը «ծննդաբերել է» երեխայի գլխի չափով միամատոզ հանգույց
 Մորն է ուղարկել դստեր մերկ լուսանկարները. աղջիկը փորձել է վերջ տալ կյանքին. քրեական գործը դատարանում է
Մորն է ուղարկել դստեր մերկ լուսանկարները. աղջիկը փորձել է վերջ տալ կյանքին. քրեական գործը դատարանում է
 ՀՀ միջպետական և հանրապետական նշանակության բոլոր ավտոճանապարհները բաց են
ՀՀ միջպետական և հանրապետական նշանակության բոլոր ավտոճանապարհները բաց են
 «Գազպրոմ Արմենիա»-ի մոտ բախվել են «Toyota»-ն, «Mercedes»-ն ու «Volvo Trailer»-ը. Shamshyan
«Գազպրոմ Արմենիա»-ի մոտ բախվել են «Toyota»-ն, «Mercedes»-ն ու «Volvo Trailer»-ը. Shamshyan
 Կարևոր՝ մինչև 2 տարեկան երեխայի խնամքի նպաստի վերաբերյալ
Կարևոր՝ մինչև 2 տարեկան երեխայի խնամքի նպաստի վերաբերյալ
 Չինաստանում հայտնաբերվել է կապիկի վիրուսի նոր բռնկում
Չինաստանում հայտնաբերվել է կապիկի վիրուսի նոր բռնկում
 20% քեշբեք AMIO Mastercard-ով
20% քեշբեք AMIO Mastercard-ով
 70-ամյա կնոջ տունը կրակը մոխրի է վերածել․ ինչ է կատարվել Նոր Խարբերդում
70-ամյա կնոջ տունը կրակը մոխրի է վերածել․ ինչ է կատարվել Նոր Խարբերդում
 Երևանում 37-ամյա վարորդը «Toyota Camry»-ով վրաերթի է ենթարկել կին հետիոտնի
Երևանում 37-ամյա վարորդը «Toyota Camry»-ով վրաերթի է ենթարկել կին հետիոտնի
 Վթարի պատճառով ջուր չի լինելու
Վթարի պատճառով ջուր չի լինելու
 -17. առաջիկա օրերի եղանակային կանխատեսումը
-17. առաջիկա օրերի եղանակային կանխատեսումը
 ՊԱՏՄՈՒԹՅԱՆ ԱՅՍ ՕՐԸ (9 ՀՈՒՆՎԱՐԻ)․ Պաշտոնապես բացվել է Նյու Յորքում գտնվող ՄԱԿ-ի շտաբ-բնակարանը. «Փաստ»
ՊԱՏՄՈՒԹՅԱՆ ԱՅՍ ՕՐԸ (9 ՀՈՒՆՎԱՐԻ)․ Պաշտոնապես բացվել է Նյու Յորքում գտնվող ՄԱԿ-ի շտաբ-բնակարանը. «Փաստ»
 Լոռիում «Nissan» է կողաշրջվել, 1 մարդ մաhացել է
Լոռիում «Nissan» է կողաշրջվել, 1 մարդ մաhացել է
 Լավ լուր՝ թոշակառուների համար․ Կառավարությունն ընդունեց որոշումը
Լավ լուր՝ թոշակառուների համար․ Կառավարությունն ընդունեց որոշումը
 Հրդեհ՝ Երևանում. այրվել է 2 տան տանիք
Հրդեհ՝ Երևանում. այրվել է 2 տան տանիք
 Ակնկալվում է ունենալ բնակչության հավասարակշռված և կայուն կառուցվածք. նախագիծ. «Փաստ»
Ակնկալվում է ունենալ բնակչության հավասարակշռված և կայուն կառուցվածք. նախագիծ. «Փաստ»
 Աբովյանում բախվել են «Hyundai Elantra»-ն ու «Jeep»-ը, վերջինը հայտնվել է կանաչ գազոնում
Աբովյանում բախվել են «Hyundai Elantra»-ն ու «Jeep»-ը, վերջինը հայտնվել է կանաչ գազոնում
 Վարժական հավաքներ կլինեն․ մանրամասներ
Վարժական հավաքներ կլինեն․ մանրամասներ
 Ամբողջությամբ այրվել է Լոս Անջելեսի ամենահին հայկական վարժարաններից մեկը
Ամբողջությամբ այրվել է Լոս Անջելեսի ամենահին հայկական վարժարաններից մեկը

 Մի՛ թողեք, որ ուրիշները որոշեն ձեր ապագան, եկե՛ք ընտրատեղամաս. ՀայաՔվե
Մի՛ թողեք, որ ուրիշները որոշեն ձեր ապագան, եկե՛ք ընտրատեղամաս. ՀայաՔվե
 Սիրով ու ջերմությամբ շնորհավորում եմ բոլորիս Երեխաների միջազգային օրվա կապակցությամբ. Ավետիք Չալաբյան
Սիրով ու ջերմությամբ շնորհավորում եմ բոլորիս Երեխաների միջազգային օրվա կապակցությամբ. Ավետիք Չալաբյան Հայաստանի ֆուտբոլի ազգային հավաքականը սկսել է ուսումնամարզական հավաքը
Հայաստանի ֆուտբոլի ազգային հավաքականը սկսել է ուսումնամարզական հավաքը
 Թող մեր երեխաները մեզանից ավելի խելացի լինեն, մեզանից ավելի լավ ապրեն. Մհեր Ավետիսյան
Թող մեր երեխաները մեզանից ավելի խելացի լինեն, մեզանից ավելի լավ ապրեն. Մհեր Ավետիսյան Իրանը Լիբանանում պшտերազմի շարունակումը համարում է hրադադարի խախտnւմ բոլոր ճակատներում. Արաղչի
Իրանը Լիբանանում պшտերազմի շարունակումը համարում է hրադադարի խախտnւմ բոլոր ճակատներում. Արաղչի
 Սամվել Կարապետյանի օգնությունը բանակին էական ու բազմազան է եղել, բավական օգտակար է եղել. Դավիթ Տոնոյան
Սամվել Կարապետյանի օգնությունը բանակին էական ու բազմազան է եղել, բավական օգտակար է եղել. Դավիթ Տոնոյան
 Փաշինյա՛ն, մենք Արևմտյան Ադրբեջան չե՛նք. Մենք՝ Հայաստա՛ն ենք. Նարեկ Կարապետյան
Փաշինյա՛ն, մենք Արևմտյան Ադրբեջան չե՛նք. Մենք՝ Հայաստա՛ն ենք. Նարեկ Կարապետյան Մուայթայ․ Կովկասի գավաթի խաղարկությունում Հայաստանի հավաքականն առաջին տեղը գրավեց թիմային հաշվարկում
Մուայթայ․ Կովկասի գավաթի խաղարկությունում Հայաստանի հավաքականն առաջին տեղը գրավեց թիմային հաշվարկում
 Հուշարձանի կարգավիճակ են ստացել 12 պատմամշակութային կառույցներ
Հուշարձանի կարգավիճակ են ստացել 12 պատմամշակութային կառույցներ
 Հայ միլիարդատիրոջ ինքնաuպան առաքելությունը. Չեխական պարբերականն անդրադարձել է Ռուբեն Վարդանյանի` Վացլավ Հավելի մրցանակի առաջադրմանը
Հայ միլիարդատիրոջ ինքնաuպան առաքելությունը. Չեխական պարբերականն անդրադարձել է Ռուբեն Վարդանյանի` Վացլավ Հավելի մրցանակի առաջադրմանը
 Ինչ սպառնալիք է ներկայացնում ԵԱՏՄ-ին Հայաստանի անդամակցության դադարեցումը
Ինչ սպառնալիք է ներկայացնում ԵԱՏՄ-ին Հայաստանի անդամակցության դադարեցումը
 Եվրոպամետ ընտրողները խաբված են և խաբվելու են, եթե չվերանայեն իրենց մոտեցումը. Էդմոն Մարուքյան
Եվրոպամետ ընտրողները խաբված են և խաբվելու են, եթե չվերանայեն իրենց մոտեցումը. Էդմոն Մարուքյան ԱՄՆ-ի կողմից ցուցաբերվող օգնությունը չպետք է օգտագործվի Հայաստանի դեմ. Թրամփն Ալիևին հուշագիր է հղել 907-րդ բանաձևի սահմանափակումների կասեցման ժամկետը երկարաձգելու մասին
ԱՄՆ-ի կողմից ցուցաբերվող օգնությունը չպետք է օգտագործվի Հայաստանի դեմ. Թրամփն Ալիևին հուշագիր է հղել 907-րդ բանաձևի սահմանափակումների կասեցման ժամկետը երկարաձգելու մասին
 Մեր պետության հայկական բովանդակությունը վտանգված է. Էդմոն Մարուքյան
Մեր պետության հայկական բովանդակությունը վտանգված է. Էդմոն Մարուքյան Այս տարի երեխաների պաշտպանության օրը հունիսի 7-ն է. պաշտպանի’ր երեխաներիդ և թոռներիդ Նիկոլից, թուրքերից, մահից և գաղթից. Արմեն Աշոտյան
Այս տարի երեխաների պաշտպանության օրը հունիսի 7-ն է. պաշտպանի’ր երեխաներիդ և թոռներիդ Նիկոլից, թուրքերից, մահից և գաղթից. Արմեն Աշոտյան
 Առավելապես երեկոյան ժամերին սպասվում է կարճատև անձրև․ եղանակն այս օրերին
Առավելապես երեկոյան ժամերին սպասվում է կարճատև անձրև․ եղանակն այս օրերին
 Մերժելով 16-ին՝ մերժում ենք Ալիևին. Արեգա Հովսեփյան
Մերժելով 16-ին՝ մերժում ենք Ալիևին. Արեգա Հովսեփյան
 Լիբանանում հրադադարը ԱՄՆ-ի հետ համաձայնագրի առանցքային պայմաններից է․ Իրանի ԱԳՆ
Լիբանանում հրադադարը ԱՄՆ-ի հետ համաձայնագրի առանցքային պայմաններից է․ Իրանի ԱԳՆ
 Կամ դու կգաս հունիսի 3-ին, կամ ադրբեջանցիները կգան
Կամ դու կգաս հունիսի 3-ին, կամ ադրբեջանցիները կգան Շնորհավորում եմ երեխաների պաշտպանության միջազգային օրվա առթիվ. Նաիրի Սարգսյան
Շնորհավորում եմ երեխաների պաշտպանության միջազգային օրվա առթիվ. Նաիրի Սարգսյան Հարցազրույց Ռոբերտ Քոչարյանի հետ. տեսանյութ
Հարցազրույց Ռոբերտ Քոչարյանի հետ. տեսանյութ
 Խաղաղության պայմանագրի տեքստի մեջ որևէ փոփոխություն չի լինելու, ավելանալու է միայն երաշխավորի գաղափարը. Ն.Կարապետյան
Խաղաղության պայմանագրի տեքստի մեջ որևէ փոփոխություն չի լինելու, ավելանալու է միայն երաշխավորի գաղափարը. Ն.Կարապետյան Կասեցվել է 10 ապoրինի հորի շահագործում․ ԲԸՏՄ
Կասեցվել է 10 ապoրինի հորի շահագործում․ ԲԸՏՄ
 Հունիսի 3-ին համար 3-ի կողքին լինելու նպատակը
Հունիսի 3-ին համար 3-ի կողքին լինելու նպատակը Ֆրանսիայում անկարգությունների հետևանքով ձերբակալվածների թիվը գերազանցել է 890-ը
Ֆրանսիայում անկարգությունների հետևանքով ձերբակալվածների թիվը գերազանցել է 890-ը
 «Համահայկական ճակատ» շարժման առաջնորդի շնորհավորական ուղերձը Երեխաների պաշտպանության օրվա առթիվ
«Համահայկական ճակատ» շարժման առաջնորդի շնորհավորական ուղերձը Երեխաների պաշտպանության օրվա առթիվ  Ուժեղ Հայաստանը քարոզարշավ է իրականացնում Նորակերտում. ուղիղ
Ուժեղ Հայաստանը քարոզարշավ է իրականացնում Նորակերտում. ուղիղ Տպավորություն է ստեղծվում, թե Թուրքիան ու Ադրբեջանը մեր ժողովրդի դեմ ռազմшկան հանցագործություններ չեն իրականացրել. Տիգրան Աբրահամյան
Տպավորություն է ստեղծվում, թե Թուրքիան ու Ադրբեջանը մեր ժողովրդի դեմ ռազմшկան հանցագործություններ չեն իրականացրել. Տիգրան Աբրահամյան
 Երևանում վաղվանից հին տրոլեյբուսներ չեն լինի. Երևան բերված 45 տրոլեյբուսից 30-ը արդեն շահագործվում են. քաղաքապետարանի պաշտոնյա
Երևանում վաղվանից հին տրոլեյբուսներ չեն լինի. Երևան բերված 45 տրոլեյբուսից 30-ը արդեն շահագործվում են. քաղաքապետարանի պաշտոնյա
 Ողբերգական հրդեհ Մեծ Մանթաշում. ներսում գտել են բնակչի դին
Ողբերգական հրդեհ Մեծ Մանթաշում. ներսում գտել են բնակչի դին
 Ինիգո Մարտինեսը նշել է այն երկու ֆուտբոլիստներին, որոնք պետք է դառնան «Բարսելոնա»-ի առաջատարները
Ինիգո Մարտինեսը նշել է այն երկու ֆուտբոլիստներին, որոնք պետք է դառնան «Բարսելոնա»-ի առաջատարները
 Ալիևին հաղթելու համար պետք է գնալ ընտրության
Ալիևին հաղթելու համար պետք է գնալ ընտրության  Բազմաթիվ անգամներ շեշտել եմ՝ ձեր վստահությունն ինձ համար ամենամեծ պատասխանատվությունն է, և ես այն պահելու ու պահպանելու եմ. Գագիկ Ծառուկյան
Բազմաթիվ անգամներ շեշտել եմ՝ ձեր վստահությունն ինձ համար ամենամեծ պատասխանատվությունն է, և ես այն պահելու ու պահպանելու եմ. Գագիկ Ծառուկյան Պուտինը շնորհավորել է Նիկոլ Փաշինյանին
Պուտինը շնորհավորել է Նիկոլ Փաշինյանին
 Սպիտակ-Գյումրի ճանապարհին մեքենա է այրվել
Սպիտակ-Գյումրի ճանապարհին մեքենա է այրվել
 Մոսկվայից զգուշացումներ՝ Երևանին․ առանց ռուսական շուկայի Հայաստանը կարող է կորցնել գյուղմթերքի արտահանման հիմնական ուղղությունը
Մոսկվայից զգուշացումներ՝ Երևանին․ առանց ռուսական շուկայի Հայաստանը կարող է կորցնել գյուղմթերքի արտահանման հիմնական ուղղությունը
 Վթար. ջուր չի լինի
Վթար. ջուր չի լինի
 «Կոմպրոմիսներով պիտի ընտրվի վարչապետ, որը նախկիններից չէ , ներկաներից չէ». Է. Մարուքյան
«Կոմպրոմիսներով պիտի ընտրվի վարչապետ, որը նախկիններից չէ , ներկաներից չէ». Է. Մարուքյան
 «Մեզ նույնիսկ ՔՊ-ում են ավելի շատ վստահում». Սամվել Կարապետյանը՝ ընտրությունների վճռորոշ նշանակության մասին
«Մեզ նույնիսկ ՔՊ-ում են ավելի շատ վստահում». Սամվել Կարապետյանը՝ ընտրությունների վճռորոշ նշանակության մասին
 Անկում տարադրամի շուկայում․ փոխարժեքն՝ այսօր
Անկում տարադրամի շուկայում․ փոխարժեքն՝ այսօր
 Հրդեհ` Մեծ Մանթաշ գյուղում
Հրդեհ` Մեծ Մանթաշ գյուղում
 Սուրբ Էջմիածնում հավատացյալների առջև ցուցադրվեցին քրիստոնեական սրբազան մասունքները
Սուրբ Էջմիածնում հավատացյալների առջև ցուցադրվեցին քրիստոնեական սրբազան մասունքները Նեթանյահուն ազգային անվտանգության նոր խորհրդական է նշանակել «Arrow 3» ՀՕՊ համակարգը ստեղծողին
Նեթանյահուն ազգային անվտանգության նոր խորհրդական է նշանակել «Arrow 3» ՀՕՊ համակարգը ստեղծողին Ամառային արձակուրդներն սկսվում են. ԿԳՄՍ նախարարի առաջարկը սովորողներին
Ամառային արձակուրդներն սկսվում են. ԿԳՄՍ նախարարի առաջարկը սովորողներին
 «Միջանցքների պատերազմ». Իրանը հայտնել է տրանսպորտային ենթակառուցվածքի ավելի քան 50 օբյեկտի վնասման մասին
«Միջանցքների պատերազմ». Իրանը հայտնել է տրանսպորտային ենթակառուցվածքի ավելի քան 50 օբյեկտի վնասման մասին Մեծ Մանթաշ գյուղում տուն է այրվել. բնակիչը մահացած է հայտնաբերվել
Մեծ Մանթաշ գյուղում տուն է այրվել. բնակիչը մահացած է հայտնաբերվել
 Բարև, «Ռեա՞լ»․ Լեաուն պաշտոնապես հայտարարել է «Միլանից» հեռանալու մասին
Բարև, «Ռեա՞լ»․ Լեաուն պաշտոնապես հայտարարել է «Միլանից» հեռանալու մասին
 Տվեք մեզ մանդատ՝ դադարեցնելու գզվռտոցը. Էդմոն Մարուքյան
Տվեք մեզ մանդատ՝ դադարեցնելու գզվռտոցը. Էդմոն Մարուքյան ԱՄՆ-ի Նյուարք քաղաքում միգրացիոն կենտրոնի մոտ անկարգություններ են բռնկվել․ սահմանվել է պարետային ժամ
ԱՄՆ-ի Նյուարք քաղաքում միգրացիոն կենտրոնի մոտ անկարգություններ են բռնկվել․ սահմանվել է պարետային ժամ Իրանի ԻՀՊԿ-ն հայտնել է Արևմտյան Ադրբեջան նահանգում հետախուզական սարքավորումների խմբաքանակի առգրավման մասին
Իրանի ԻՀՊԿ-ն հայտնել է Արևմտյան Ադրբեջան նահանգում հետախուզական սարքավորումների խմբաքանակի առգրավման մասին 






